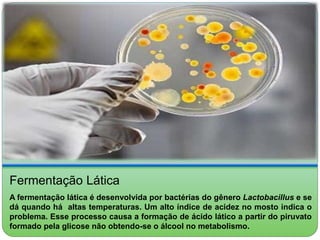
Fermentação Lática 
A fermentação lática é desenvolvida por bactérias do gênero Lactobacillus e se 
dá quando há altas temperaturas. Um alto índice de acidez no mosto indica o 
problema. Esse processo causa a formação de ácido lático a partir do piruvato 
formado pela glicose não obtendo-se o álcool no metabolismo.

O documento descreve o processo de fermentação alcoólica em uma destilaria. Inclui a chegada do caldo clarificado e adição de mel, o tratamento da levedura em cubas, e as três fases da fermentação: preliminar, tumultuosa e complementar. As dornas primárias e secundárias são usadas na fase preliminar, enquanto a fase tumultuosa apresenta grande formação de espuma.